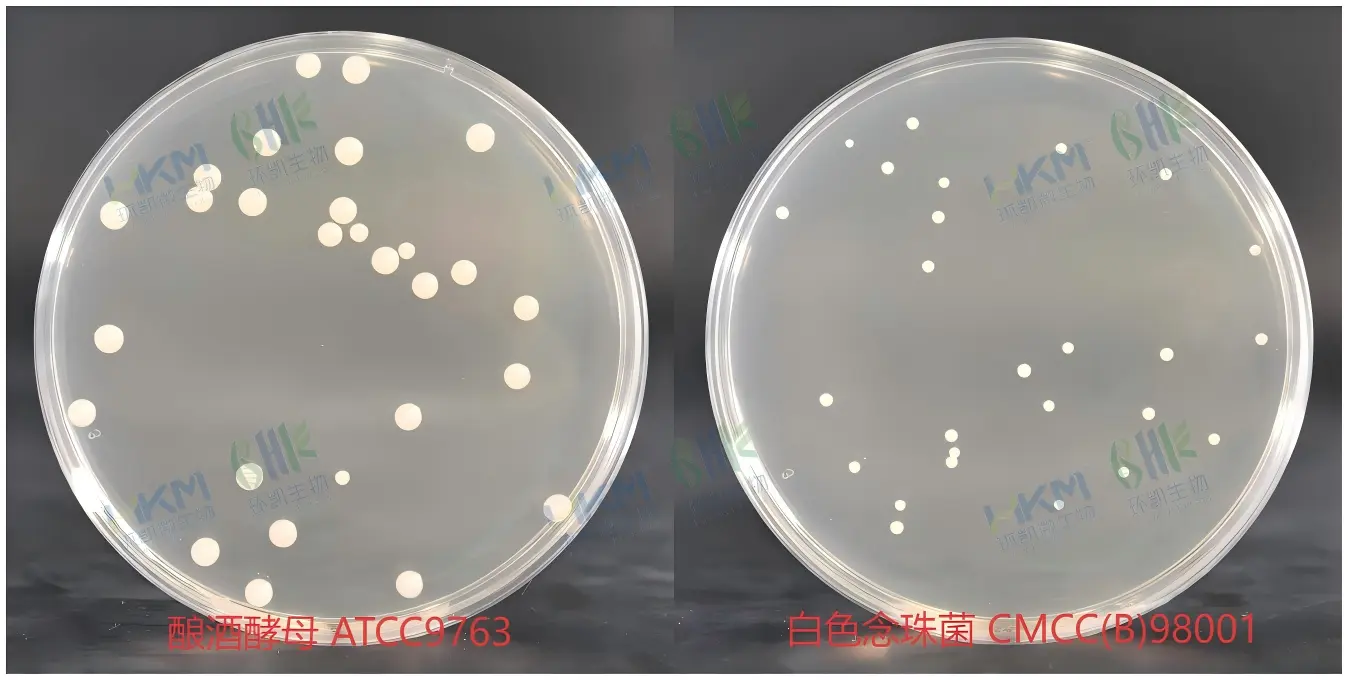
酵母浸出粉胨葡萄糖琼脂培养基(YPD)菌落特征

商品详细
说明书
微生物图册
行业应用
相关论文
产品名称:酵母浸出粉胨葡萄糖琼脂(YPD)平板
英文名称:Yeast Extract Peptone Dextrose Agar(Plate)
其它叫法:YPD平板培养基,YPD琼脂平板
产品编号与包装规格:
| 产品编号 | 产品类型 | 包装规格 |
|---|---|---|
| 021100B | 即用成品 | 90mm×20个/盒 |
产品用途:用于酵母菌的培养,及供药品和生物制品中含王浆和蜂蜜的合剂酵母菌数测定用。
YPD平板培养基(酵母浸出粉胨葡萄糖琼脂)配方成分:
| 配方(每升) | 含量 |
|---|---|
| 胨 | 10.0g |
| 酵母浸出粉 | 5.0g |
| 葡萄糖 | 20.0g |
| 琼脂 | 14.0g |
| 蒸馏水 | 1000mL |
| 最终pH 6.0±0.2 | |
使用方法:待检样品按照相应的标准(《中华人民共和国药典》2010年版、GB、FDA 等)制备样品稀释液,选取2~3 个适宜的稀释度,采用涂布法进行计数,每个稀释度平行接种两块;也可以划线接种该培养基平板,按相应标准培养条件进行培养,观察结果。
YPD平板培养基(酵母浸出粉胨葡萄糖琼脂)质量控制(下列质控菌株接种待测试培养基,20-25℃,72h结果如下:):
| 指标 | 质控菌株及编号 | 生长率 | 特征性反应 |
|---|---|---|---|
| 生长率 | 白色念珠菌CMCC(B)98001 | PR:0.5~2.0 | 奶油色菌落 |
| 酿酒酵母ATCC9763 | PR:0.5~2.0 | 奶油色菌落 |
储存条件与有效期:2-25℃贮存于避光、干燥处;有效期见于产品标签。
注意事项:一次性平板培养基置于冰箱冷藏保存需与存放容器冷凝管保持一定距离以避免冻损坏。产品多次在低温与常温之间变更会引起琼脂的泌水,属于正常现象。使用前应平衡至室温且尽量在无菌干燥箱中预干燥。
参考文献:《中华人民共和国药典》2010年版
酵母浸出粉胨葡萄糖琼脂(YPD)平板 相关成品培养基产品【用于真菌(霉菌、酵母、食用菌)检测)】:
| 产品名称 | 产品货号(类型) | 规格 | 产品说明及用途 |
| 孟加拉红(虎红)琼脂平板 | 021010B(成品平板) | 90mm×20个/盒 | 供霉菌和酵母菌的计数、分离、培养用(GB、SN、化妆品卫生规范) |
| 念珠菌显色培养基平板 | CRM010P1(成品平板) | 90mm×20个/盒 | 用于念珠菌特别是白色念珠菌的选择性分离和初步鉴别(WS) |
| 沙氏琼脂斜面培养基 | CP0480(成品斜面) | 8mL×20支/盒 | 用于真菌的分离培养,还用于一次性使用卫生用品真菌菌落总数检测(GB) |
| 沙氏琼脂培养基平板 | CP0170(成品平板) | 90mm×20个/盒 | |
| 沙氏液体培养基(成品瓶装) | CP1091P1(成品瓶装) | 50ml×40瓶/箱 | 用于真菌的分离培养,还用于一次性使用卫生用品真菌定性检测(GB) |
| 沙氏葡萄糖琼脂(SDA)平板 | C21098B1(成品平板) | 90mm×20个/盒 | 用于霉菌和酵母菌培养及总数计数(ChP、ISO、EP、USP、美国FDA、WS) |
| 沙氏葡萄糖琼脂(SDA)斜面培养基 | C21098G1(成品斜面) | 10mL×20支/盒 | |
| 沙氏葡萄糖肉汤(SDB)培养基(瓶装) | CP1096P1(成品瓶装) | 100mL×40瓶/箱 | 用于霉菌和酵母菌培养(ChP、ISO、EP、USP、美国FDA) |
| 沙氏葡萄糖液体(SDB)培养基(管装) | CP1096G1(成品管装) | 10mL×20支/盒 | |
| 马铃薯葡萄糖琼脂(PDA)平板 | CP0010(成品平板) | 90mm×20个/盒 | 供霉菌和酵母菌计数及分离培养(ChP) |
| 马铃薯葡萄糖琼脂(PDA)斜面培养基 | CP0120(成品斜面) | 7mL×20支/盒 | |
| 玫瑰红钠琼脂平板 | 024088(成品平板) | 90mm×20个/盒 | 供药品及生物制品中霉菌和酵母菌的计数、分离、培养用(ChP) |
| 孟加拉红(虎红)琼脂平板 | 021010B(成品平板) | 90mm×20个/盒 | 供霉菌和酵母菌的计数、分离、培养用(GB、SN、化妆品卫生规范) |
